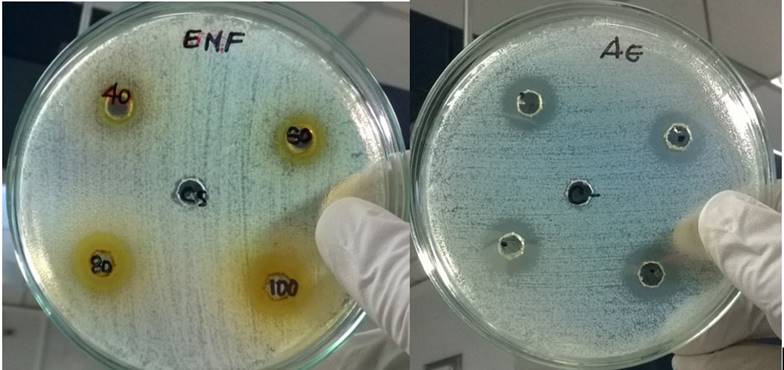

Introducción
Ralstonia solanacearum causa grandes pérdidas económicas a los cultivadores de plátano, tabaco y tomate. La infección con esta bacteria reduce la producción en estos cultivos a través de los daños que causa en el sistema vascular de la planta y en consecuencia a todas sus partes (hojas, flores, frutos, tallos), llevando a la enfermedad conocida como Moko o marchitez bacteriana. El control de R. solanacearum, es lograda principalmente a través de la eliminación del cultivo y la posterior cuarentena de los suelos, porque muy poco se ha logrado con bactericidas sintéticos debido a la alta capacidad de supervivencia de la bacteria (Ceballos et al., 2014; Kheirandish y Harighi, 2015), por lo tanto, el uso de extractos de plantas como agentes de control para esta bacteria es un área de investigación promisoria, no solo por su bajo costo y la seguridad para la salud humana, sino por ser amigable con el ambiente.
El género Tagetes son hierbas perennes anuales, de 20 a 30 cm de altura, que pertenece a la familia de las Asteraceae. Esta planta originaria de norte y sur América, pero con amplia distribución mundial, es usada en la medicina tradicional de muchas regiones del mundo. Existen cerca de 30 especies de Tagetes, las más estudiadas son T. patula, T. minuta y T. erecta (Xu et al., 2012). Como resultado de estos estudios, se han descrito varios componente de sus extractos y del aceite esencial, que incluyen: benzofuranos, carotenoides, flavonoides y tiofenos tales como: terpineol, (Z)-ocimeno, dihidrotagetona, (E)-ocimenona, (Z)-tagetona, and (Z) ocimenona, piperitona, que son biológicamente activos y potencialmente alelopáticos contra muchos organismos patógenos como hongos, bacterias, virus nematodos, insectos, garrapatas entre otros (Hooks et al., 2010; Andreotti et al., 2013; Politi et al., 2016). Sin embargo, el rol de estos compuestos no ha sido plenamente caracterizado contra R solanacearum, dado que el control de esta bacteria es problemático, hay necesidad de encontrar nuevas estrategias de control.
Basados en la fitoquímica descrita en recientes estudios de T. patula L., como es su riqueza en flavonoides y terpenoides y su potencial biocida, la presente investigación tuvo como objetivo. 1) analizar el potencial antioxidante de los extractos y el AE de T. patula; y 2) determinar el efecto de los extractos y el AE sobre el crecimiento de R. solanacearum.
Materiales y métodos
Material vegetal
Las flores frescas de Tagetes patula L., fueron colectadas de plantas sembradas en la finca La Alsacia, Buenavista, Quindío (4° 21’ 35’’ latitud norte - 75° 44’ 21’’ longitud oeste. 1 450 msnm. Cordillera central), se realizó la determinación taxonómica y se depositó un espécimen en el herbario de la Universidad del Quindío (HUQ) (registro #36926, código #12929).
Preparación de extractos
El material vegetal (hojas y flores), fue lavado y secado en un horno a 40 °C y posteriormente pulverizado.
Los extractos metanólicos de hojas (EMH) y flores (EMF) secas y pulverizadas de T. patula, se obtuvieron mediante percolación continua con metanol anhidro por dos semanas, la solución se filtró y se concentró utilizando un rotaevaporador (marca Heydolf), finalmente fueron liofilizados hasta alcanzar una humedad aproximada de 5%.
Las clorofilas del EMH, fueron separadas por la acción de una mezcla Etanol- Agua que permite precipitarlas, la solución obtenida se filtró al vacío y se concentró en un evaporador rotatorio a presión reducida y a una temperatura de 38 °C. Este extracto fue liofilizado hasta obtener un extracto con aproximadamente 5% de humedad.
Análisis fitoquímico de los extractos de T. patula
Se evaluó el EMH y el EMF, para la identificación de taninos, saponinas, flavonoides, quinonas, esteroles, triterpenoides, naftoquinonas y antraquinonas, glucósidos cardiotónicos, lactonas terpénicas y alcaloides siguiendo métodos de identificación estándares (Carvajal-Rojas et al., 2009).
Actividad antioxidante DPPH
La actividad antioxidante fue determinada por la captación de radicales libres del 1.1-difenil-2-picrilhidrozyl (DPPH˙) aplicando la metodología descrita por Guha et al. (2010 y 2011). Se evaluaron diferentes concentraciones de los extractos de T. patula, EM (35, 25, 15, 8, 4, 2 µg mL-1), preparadas en metanol, y AE (3, 2.6, 2.1, 1.7, 0.9, 0.65 mg mL-1). Los extractos reaccionaron con el DPPH por 30 min en la oscuridad, luego se leyeron a 517 nm en espectrofotómetro génesis 5. El cálculo de la actividad antioxidante se realizó con la fórmula: actividad antioxidante (%)= (control-muestra)/(control)*100.
Determinación de fenoles totales
El método Folin-Ciocalteu Stagos et al. (2012) fue utilizado para le determinación del contenido fenólico total de los extractos, con ácido gálico como muestra patrón. Para cada muestra se utilizó 1 mg/ml de cada extracto, todos los ensayos se realizaron por triplicado y los resultados son expresados como mg de ácido gálico/g de extracto (mg AG g-1).
Obtención y análisis del aceite esencial de T patula
La extracción del aceite esencial (AE) se realizó por destilación con arrastre de vapor según algunas modificaciones al método de Leal y colaboradores Torres et al. (2013), brevemente: 3 kg de hojas y flores (50:50 de hojas y flores frescas), fueron sometidas a un proceso de destilación por arrastre de vapor de agua (temperatura ±100 °C), para la obtención de los compuestos volátiles el condensador se mantuvo entre 0 y 4 °C. El aceite esencial se separó, por el método de extracción líquido - líquido, con acetato de etilo el cual fue retirado por rotaevaporación. El aceite esencial se conservó en un frasco de color ámbar y en refrigeración, para su posterior análisis.
Determinación de los componentes del aceite esencial
Se realizó en un cromatógrafo de gases acoplado a un espectrómetro de masas (CG/EM) zhimadzu, modelo GC: autosystem. TemXL, MS: turbo más en las siguientes condiciones: Columna Rtx©-5 de 30 m de largo, diámetro 0.25 μ, temperatura de inyección: 240 °C, volumen de inyección: 5 μL. La de tección de los componentes químicos fue por comparación con los estándares de espectros de masas de las respectivas bibliotecas. El porcentaje relativo de los compuestos individuales fue determinado con base al método de normalización del área bajo el pico usando factores de corrección.
Actividad antibacteriana
Cepas de Ralstonia solanacearum raza 2
Las cepas fueron aisladas de material vegetal (frutos de plátano Dominico harton) infectado con Moko e identificadas como Ralstonia solanacearum raza 2 por comparación morfológica y biología molecular, con una cepa control R. solanacearum raza 2 CIAT 1040 proporcionada por el Centro Internacional de Agricultura Tropical (CIAT) Palmira-Colombia.
Para todos los ensayos de actividad antimicrobiana se utilizó el método de difusión en agar (Montiel et al., 2016), el método se fundamenta en la difusión del aceite esencial en medio sólido alrededor de la excava ción de 6 mm realizada con un sacabocados. Inicialmente se preparó el inóculo de estándar, se tomó una asada del cultivo de R. solanacearum raza 2 y se suspendió en 5 mL de solución salina estéril hasta alcanzar la turbidez de 0.5 de la escala de Mc Farland equivalente a 1.5x109 UFC mL-1. Se distribuyó este inóculo sobre el agar solido cuidadosamente con un hisopo estéril, pasados 15 min de fijación de los microorganismos en el agar se realizaron las perforaciones con el sacabocados y se adicionaron 25 µL del aceite esencial.
Además, en placas separadas se probaron diferentes concentraciones de los extractos metanólicos de T. patula de 40, 60, 80 y 100 mg mL-1. Se adicionó 25 µL de cada concentración en las excava ciones de 6 mm. Las placas se incubaron a 30 °C. El efecto antimicrobiano fue dado por el diámetro de la zona de inhibición.
Resultados y discusión
Análisis fitoquímico de los extractos de T. patula
El análisis fitoquímico preliminar de los extractos EMH y EMF, demostró la presencia de algunos metabolitos secundarios, tales como taninos, saponinas, flavonoides, terpenos, quinonas, azúcares entre otros descritos en el Cuadro 1.
Cuadro 1 Análisis fitoquímico de los extractos metanólicos de T. patula L.
| Metabolito | EMH | EMF |
|---|---|---|
| Taninos | + | +++ |
| Flavonoides | ++ | +++ |
| Quinonas | - | ++ |
| Cardiotónicos | - | - |
| Desoxiazucares | + | + |
| Azúcares | ++ | +++ |
| Cumarinas, lactonas terpénicas | ++ | ++ |
| Esteroides y triterpenoides | + | ++ |
EMH= extracto metanólico de hojas; EMF= extracto metanólico de flores; += presencia; -= ausencia.
Los compuestos más abundantes para el extracto metanólico de hojas fueron flavonoides, azúcares y cumarinas, lactonas terpénicas, para el de flores fueron taninos, flavonoides y azúcares.
Los metabolitos secundarios encontrados en este trabajo en los extractos metanólicos de hojas y flores de T patula, también han sido identificados por otros autores, por ejemplo, en esta planta, se han descritos más de doce flavonoides, como quercetagetina y sus derivados, kaempferol, kaempferitrina y sus derivados, miricetina y sus derivados, patuletina, y luteína entre otros. También esteroides como β-sitosterol y colesterol (Xu et al., 2012). Muchos de estos compuestos muestran un alto potencial para ser incluidos como nuevos medicamentos o como pesticidas (Raut y Karuppayil, 2014; Politi et al., 2016). También otras aplicaciones como su actividad antioxidante, emergen gradualmente de los estudios de los compuestos de Tagetes spp. (Raut y Karuppayil, 2014).
La cromatografía gas-masa del aceite esencial de hojas y flores, permitió hacer una identificación más detallada de algunos de estos compuestos y sus propiedades como se describe más adelante.
Actividad antioxidante DPPH
El EMF tuvo la mayor capacidad captadora de radicales libres DPPH, así: 35 µg mL-1 de EMF, capataron 89.52%, 120 µg mL-1 EMH 85.95% y 3 mg/ml de AE (42.41%). La concentración que posee 50% de captación de los radicales DPPH se estableció para el EMF en 13.21 µg mL-1 y para el EMH: 52.85 mg ml-1: para el aceite esencial no fue posible establecerla, ya que su concentración no fue comparable con el estándar.
Determinación de fenoles totales
El EMF exhibió el mayor contenido fenólico con 227.67 µg Eq- de ácido gálico/mg de EMF, seguido por el EMH con 153.48 µg Eq- de ácido gálico/mg de EMH, mientras que el AE de flores y hojas, tuvo el menor contenido fenólico con 14.44 g Eq- de ácido gálico/mg de AE.
Diferentes trabajos de investigación relacionan el contenido de compuestos fenólicos (incluidos los flavonoides) en plantas con su capacidad de eliminar los radicales libres (Al Dhaheri et al., 2013). En este estudio se encontró una relación entre el contenido fenólico de los extractos y su capacidad captadora de radicales libres, ya que los extractos con mayor contenido fenólico resultaron tener mayor capacidad de captación de radicales libres DPPH. Por otro lado, varios autores han demostrado altos valores de actividad antioxidante del género Tagetes (Kazibwe et al., 2017).
Aún más se ha demostrado que los diferentes compuestos aleloquímicos con potencial actividad antioxidante, no solo están involucrados en los mecanismos de defensa de la planta, sino que pueden ser responsables de la actividad citotóxico observada en este género (Politi et al., 2016); como se evidencia en los resultados contra R solanacearum, que se describen más adelante. Sin embargo, es necesario realizar más estudios sobre la citotoxicidad de estos compuestos y su capacidad antioxidante.
Componentes del aceite esencial de T. patula
La destilación por arrastre de vapor de flores de T. patula proporcionó 1 ml kg-1 de aceite esencial. El análisis cualitativo y cuantitativo del mismo, realizado por cromatografía de gases- masa permitió la identificación de veinte compuestos (Figura 1).
Los mayores componentes fueron seis, en orden ascendente: Indane 5.47%, D-limoneno 5.76%, Z-ocimeno 5.98%, terpinoleno 6.73%, Bervenona 19.98% y la piperitona con 40.4%, representando estos seis 84.02% de los componentes identificados, los cuales son descritos en el Cuadro 2.
Cuadro 2 Composición química del aceite esencial de hojas y flores de Tagetes patula, expresados como porcentajes.
| Número pico |
Tiempo de retención |
Compuestos | Sinónimos | Abundancia (%) |
|---|---|---|---|---|
| 1 | 5.233 | Butyl ester | Acetato de n -butilo | 3.62 |
| 2 | 6.503 | 2- hexanal | (E)-2-hexenal | 0.81 |
| 3 | 6.76 | 3- hexen- 1- ol | Cis-3- hexenol | 1.31 |
| 4 | 7.173 | 2- hexen- 1-ol | (E)-2-hexenol | 0.39 |
| 5 | 7.301 | 1-hexanol | Alcohol hexílico | 0.57 |
| 6 | 7.527 | 1-butanol, 3-methyl- acetate | Isoamyl acetate | 0.1 |
| 7 | 7.619 | 1-butanol 2-methyl- acetate | 1-2-methylbutanol acetate | 0.23 |
| 8 | 11.006 | Beta- phellandrene | Phellandrene | 0.48 |
| 9 | 11.737 | Beta- myrcene | Mirceno | 0.59 |
| 10 | 12.313 | 3-Hexen- 1-ol | Cis-3-hexenol | 0.42 |
| 11 | 13.048 | D- limonene | Limonene | 5.76 |
| 12 | 13.404 | Trans- beta- ocimene | Trans- β- ocimene | 1.98 |
| 13 | 13.804 | 1,3,6- octadien- 3- ol, | Z- ocimene | 5.98 |
| 14 | 15.075 | 1- methyl-4-(1-methylethylidene) | Terpinolene | 6.43 |
| 15 | 15.468 | 1, 6-octadien-3-ol | Linalool | 1.84 |
| 16 | 17.81 | Terpinen-4-ol | Terpinen-4-ol | 1.37 |
| 17 | 20.604 | 2- cyclohexen-1-one | Piperitone | 40.4 |
| 18 | 21.501 | Indane | Indane | 5.47 |
| 19 | 22.858 | 2- pinen- 4-one | Verbenone | 19.98 |
| 20 | 24.68 | Caryophyllene | Caryophyllene | 2.27 |
Compuestos similares fueron descritos por Prakash et al. (2012), para las inflorescencias de Tagetes patula, ellos encontraron que los mayores componentes del aceite esencial de esta variedad fueron: 1.8-cineola (4.4%), (Z)-Beta-ocimeno (11.8%), terpinoleno (6.9%), (Z)-ocimenone (6.4%), (E)-ocimenona (3%), gama-elemeno (16.9%), piperitenona (3.3%), β -caryophyleno (18.6%) and (E)-β-ionone (2.5%). Muy similares a los encontrados en este trabajo, pero en menores porcentajes como la piperitona. También Kyarimpa et al. (2014), en aceite esencial de Tagetes minuta, identificó nueve componentes mayores, tres de los cuales coinciden con los identificados como mayores en el presente trabajo, a saber, limoneno 8%, Beta-trans ocimeno 15.9% y verbenona 16.8%.
Estas diferencias en componentes y los porcentajes relativos puede deberse a factores ambientales y estacionarios relacionados con el cultivo de las plantas, a la localización geográfica, a la parte de la planta empleada, a la especie misma (T. patula, T. erecta, T. minuta), a la cantidad del material fresco, a los sistemas de extracción, aunque estos son muy similares y a la cantidad de irrigación como ha sido descrito por Umar et al. (2017) para T. patula y T. erecta, sometidas a diferentes estrategias de déficit de irrigación. Ellos encontraron que componentes de los aceites esenciales como el cariofileno, terpinoleno entre otros, pueden aumentar en estados de estrés por déficit de agua en distintas especies de Tagetes.
Actividad antibacteriana
Una vez obtenido los extractos metanólicos y el aceite esencial se probó su efecto antibacteriano contra R. Solanacerum raza 2.
Ralstonia solanacearum race 2 (Smith, 1896) es una bacteria Gram-negativa, en forma de bacilo que produce la enfermedad del Moko o marchites bacteriana, la cual afecta el sistema vascular de plantas como plátano, banano, tabaco y tomate, entre otras. El Moko ha causado grandes estragos en los cultivares de papa, tabaco, plátano y banano en el mundo.
Se han planteado muchas estrategias para combatir el Moko, entre ellas cultivar variedades resistentes y plantas transgénicas, o el uso de pesticidas de origen natural o químico (Ceballos et al., 2014; Liu et al., 2016), pero todas ellas con limitados éxito, debido a la capacidad de supervivencia en entornos complejos, amplia gama de huéspedes, amplia distribución geográfica y diversidad genética de R. solanacearum (Ceballos et al., 2014; Kheirandish y Harighi, 2015).
Los resultados del presente estudio muestran que el EMH no posee actividad antibacteriana frente R. solanacearum, mientras el EMF presentó una inhibición dependiente de la concentración, pero R. solanacearum raza 2, resultó ser muy sensible al AE de T. patula. Los diámetros para los halos de inhibición son mostrados en el Cuadro 3 y la Figura 2.
Cuadro 3 Actividad antibacteriana de extractos de T. patula vs Ralstonia solanacearum raza 2.
| Concentración (mg mL-1) |
Halo de inhibición bacteriana del EMF (mm) |
Resultados |
|---|---|---|
| 40 | 10 | Sensibilidad limite (sensible = +) |
| 60 | 11 | Sensibilidad limite (sensible = +) |
| 80 | 15 | Media (muy sensible = ++) |
| 100 | 16 | Media (muy sensible = ++) |
| Concentración (%) | Halo de inhibición bacteriana del AE (mm) | Resultado |
| 100 | 16 | Media (muy sensible = ++) |
Figura 2 Halos de inhibición del aceite esencial (AE) y el extracto metanólico de flores (EMF) frente a Ralstonia solanacearum raza 2.
Al respecto, existen varios estudios que demuestran la capacidad fungicida, larvicida e insecticida del aceite esencial del genero Tagetes (Hooks et al., 2010; Andreotti et al., 2013; Politi et al., 2016). También otros estudios con extractos de diferentes plantas diferentes al género Tagetes han demostrado un efecto antibacteriano contra R solanacearum, así Bay et al. (2016), demostraron que el eugenol, un compuesto del extracto etanólico de flores de Syringa oblata inhibe significativamente el crecimiento de R. solanacearum (radio de inhibición de 18.5 mm). Muy similar al radio de inhibición encontrado en nuestro trabajo (diámetro 16 mm con el AE). Del mismo modo, Li y colaboradores (Li et al., 2014) usando Lansiumamide B, el cual es aislado de semillas de Clausena lansium demostró que este compuesto inhibe completamente el crecimiento de R. solanacearum a concentración de 125 mg L-1 in vitro. Estos y otros estudios muestran la sensibilidad de R. Solanacearum a diferentes compuestos de origen vegetal.
Al respecto, existen varios estudios que demuestran la capacidad fungicida, larvicida e insecticida del aceite esencial del genero Tagetes (Hooks et al., 2010; Andreotti et al., 2013; Politi et al., 2016). También otros estudios con extractos de diferentes plantas diferentes al género Tagetes han demostrado un efecto antibacteriano contra R solanacearum, así Bay et al. (2016), demostraron que el eugenol, un compuesto del extracto etanólico de flores de Syringa oblata inhibe significativamente el crecimiento de R. solanacearum (radio de inhibición de 18.5 mm). Muy similar al radio de inhibición encontrado en nuestro trabajo (diámetro 16 mm con el AE). Del mismo modo, Li y colaboradores (Li et al., 2014) usando Lansiumamide B, el cual es aislado de semillas de Clausena lansium demostró que este compuesto inhibe completamente el crecimiento de R. solanacearum a concentración de 125 mg L-1 in vitro. Estos y otros estudios muestran la sensibilidad de R. Solanacearum a diferentes compuestos de origen vegetal.
En esta investigación y por primera vez hasta donde se conoce, se describe el efecto antibacteriano del extracto metanólico de flores y del aceite esencial de T. patula contra R solanacearum raza 2. T. patula (Asteraceae) es una hierba perenne anual que pertenece a la familia de las Asteraceae. Algunos componentes de los extractos y del aceite esencial de T. patula se han descrito previamente (Prakash et al., 2012; Xu et al., 2012; Politi et al., 2016), estos componentes son similares a los encontrados en el presente estudio como ya se ha mencionado. Estos compuestos son biológicamente activos y potencialmente alelopáticos contra diversos patógenos.
Aunque el rol de cada uno de los compuestos no se ha identificado plenamente, se observó por ejemplo, que los flavonoides y los terpenoides tienen potente actividad anti bacterial, estos resultados muestran, que el extracto metanólico de flores y el aceite esencial de T. patula, son ricos en flavonoides y terpenoides, de estos últimos la piperitona y la verbenona fueron fue los más abundantes en el aceite esencial (40.4 y 19.98% respectivamente), a estos compuesto se les han atribuido una importante actividad antimicrobiana, específicamente bactericida, así Brahmi y colaboradores encontraron, que el principal componente del aceite esencial de Mentha rotundifolia L. fue la el epóxido de trans-Piperitona (30.2%) y el óxido de piperitona (8.7%) y este aceite esencial logró la inhibición del crecimiento de diversas bacterias (Escherichia coli y Pseudomonas aeruginosa) entre otras (Brahmi et al., 2016). Mientras Scollard et al. (2016) Encontró que la verbenona inhibe el crecimiento de Listeria monocytogenes.
Sin embargo, en el presente estudio no se evaluaron el efecto de estos compuestos individuales por lo que solo se puede sugerir que tales componentes o una mezcla de ellos pueden ser responsables de la capacidad de inhibición de R. solanacearum, señalando la necesidad de seguir profundizando en los componentes del aceite esencial y sus efectos sobre esta bacteria.
Conclusiones
El EMF posee la mayor capacidad captadora de radicales libres (DPPH) comparado con el AE posiblemente relacionado con su mayor contenido de fenoles, lo que lo muestra como un potencial candidato para desarrollar medicamentos contra el estrés oxidativo. El extracto metanólico de flores de T. patula tiene un alto contenido en flavonoides y terpenoides. Mientras la composición del aceite esencial de hojas y flores mostró un alto contenido de piperitona y verbenona. Tanto el EMF como el AE inhibieron el crecimiento bacteriano, pero el AE fue más efectivo. Basados en los resultados de este trabajo, el extracto metanólico de flores y aceite esencial de flores y hojas de T. patula puede ser una opción para el control R. solanacearum raza 2.











 texto en
texto en 



